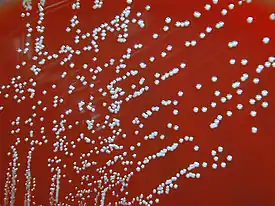

Бруцеллы
Бруце́ллы[2] (лат. Brucella) — род бактерий из семейства Brucellaceae класса альфа-протобактерий. Назван в честь шотландского военного врача Дэвида Брюса, который первым выделил и описал микроогранизмы на Мальте в 1887 году.
| Бруцеллы | ||||||||||
|---|---|---|---|---|---|---|---|---|---|---|
![]() Brucella melitensis | ||||||||||
| Научная классификация | ||||||||||
|
Домен: Тип: Класс: Альфа-протеобактерии Порядок: Ризобиевые Семейство: Brucellaceae Род: Бруцеллы |
||||||||||
| Международное научное название | ||||||||||
| Brucella Meyer and Shaw 1920 | ||||||||||
| Виды[1] | ||||||||||
|
||||||||||
| ||||||||||
Люди могут подвергаться заражению при вдыхании зараженной пыли или аэрозолей, и поэтому Центр по контролю и профилактике заболеваний США пометил виды Brucella как боевые, пригодные для использования в качестве биологического оружия. По состоянию на август 2013 г., профессор Эллисон Райс-Фихт из Техасского университета A&M и её команда утверждают, что близки к созданию вакцины для человека. В первую очередь он будет использоваться для иммунизации военнослужащих в случае контакта с боевым и штаммами бруцеллы на поле боя[3].
Морфология и физиология микроорганизмов
Род грамотрицательных, мелких коккобактерий или палочковидных бактерий (~0,5-2,5 мкм). Имеют микрокапсулу, не образуют спор, не имеют жгутиков. Отличаются выраженным полиморфизмом, особенно в молодых культурах. Хемоорганотрофы, каталаза- и оксидазаположительны (кроме Brucella ovis и Brucella neotomae). Строгие аэробы, температурный оптимум 37 °C. Размножаются достаточно медленно, поскольку при первоначальном выделении лучше растут в атмосфере 5-15% углекислого газа. Они способны к внутриклеточному размножению, что ведёт к их длительному пребыванию в организме. Требовательны к составу питательных сред.
Лабораторная диагностика
Выявляются непосредственно в патологическом материале с помощью реакции прямой и непрямой иммунофлуоресценции (РИФ и РНИФ). При отрицательных результатах бактериологических и серологических исследований ставят кожные аллергические пробы с бруцеллином (белковым экстрактом культуры).
Культивирование на питательных средах
Для культивирования in vitro используют печёночный агар или печёночный бульон. Лишь некоторые штаммы бруцелл ферментируют декстрозу, галактозу, ксилозу, левулезу, арабинозу. Бруцеллы могут синтезировать каталазу, пероксидазу, липазу, фосфатазу. Бруцеллы не разжижают желатин, не свертывают молоко, не обладают гемолитической активностью. Факторами роста являются тиамин, ниацин, биотин. Бруцеллы хорошо растут на агаре из картофельного настоя с сывороткой крови, на сывороточно-декстрозном агаре, триптозно-соевом агаре, триптозном агаре, агаре Альбими, агаре Д. В настоящее время широко используется коммерческая среда для выделения бруцелл – эритрит-агар или бруцеллагар. Для выделения бруцелл из загрязненных посторонней микрофлорой материалов к питательным средам добавляют антибиотики (полимиксин, бацитрацин и др.), угнетающие постороннюю микрофлору и не препятствующие росту бруцелл. При первичном выделении бруцелл из инфицированного материала колонии формируются через 1-3 недели после посева.
Геном
Бруцеллы геном включает в себя две хромосомы: первая хромосома кодирует в основном гены, связанные с метаболизмом, а вторая (меньшая по размеру) включает несколько генов, связанных с патогенностью. Геномы большинства видов Brucella были секвенированы и обычно кодируют от 3200 до 3500 открытая рамка считывания[4]
- Brucella abortus A13334, 3,401 ORFs
- Brucella canis ATCC 23365, 3,408 ORFs
- Brucella melitensis 16M, 3,279 ORFs
- Brucella microti CCM 4915, 3,346 ORFs
- Brucella ovis ATCC 25840, 3,193 ORFs
- Brucella pinnipedialis B2/94, 3,505 ORFs
- Brucella suis 1330, 3,408 ORFs
Данные генома для этих и других штаммов Brucella доступны в базах данных GOLD[4] и PATRIC[5] . Кроме того, была создана общедоступная и редактируемая электронная таблица с аннотациями генома B. abortus 2308W , которая будет обновляться на основе новых открытий.
Патогенность и патогенез
| Фактор патогенности бруцеллы | Биологический эффект |
|---|---|
| Микрокапсула | Препятствие фагоцитозу |
| Эндотоксин | Лихорадка |
| Гиалуронидаза, нейраминидаза, каталаза, уреаза | Разрушение тканевых барьеров, подавление активных форм кислорода |
| Белки наружной мембраны | Адгезия микробных клеток |
Бруцеллы обладают высокой проникающей способностью, внедряются в организм даже через неповреждённые слизистые оболочки пищеварительного тракта, лёгких, глаз, кожу, распространяются по лимфотоку и депонируются в лимфатических узлах. Бруцеллы сохраняются внутри фагоцитов, выделяя низкомолекулярные факторы, ингибирующие слияние фагосом с лизосомами. Внутри фагоцитов бруцеллы могут переходить в L-формы и длительно персистировать, что приводит к появлению гранулём.Процесс поглощения бруцелл и их высвобождения из фагоцитов многократно повторяется, . Поэтому течение болезни принимает характер хрониосепсиса с периодическими рецидивами и аллергизацией организма рецидив болезни. Из разрушенных макрофагов бруцеллы через кровоток попадают в печень, селезёнку, почки, костный мозг и эндокард.Температура тела пациента при этом обычно повышается во второй половине дня; падение температуры в ночное время сопровождается обильным потоотделением - ундулирующая лихорадка. Бруцеллёзная лихорадка длительная, сохраняющаяся месяцами.
Резистентность
Бруцелла относительно устойчива к воздействиям окружающей среды:
| Факторы среды | Устойчивость |
|---|---|
| во влажной почве и воде | до 4,5 месяцев |
| в молоке | до 273 дней |
| в кефире | до 11 дней |
| в замороженном мясе | до 60 дней |
| при 55С | погибают в течение 1 часа |
| прямые солнечные лучи | в течение 4,5 часов |
Эпидемиология
На сентябрь 2015 г. выделено 11 видов бруцелл, из которых 4 вида:
- Brucella melitensis (мальтийская) козье-овечий вид, возбудитель бруцеллеза мелкого рогатого скота (овец, коз), патогенен для человека, имеет 3 биовара (биотипа)[6],
- Brucella abortus (Brucella bovis, бычья) коровий вид, возбудитель бруцеллеза крупного рогатого скота (болезни Банга), патогенен для человека, включает 7 биоваров (биотипов)[6],
- Brucella suis (свиная) свиной вид, возбудитель бруцеллеза свиней, патогенен для человека, имеет 5 биоваров (биотипов); носителем 2-го биовара являются также зайцы, 4-го биовара - олени, а 5-го биовара - мышевидные грызуны[6],
- Brucella canis (собачья) — вызывают болезнь у человека — патогенен для человека[6],
- Brucella neotomae - возбудитель бруцеллеза кустарниковых (лесных) крыс[6],
- Brucella ovis - возбудитель инфекционного эпидидимита баранов и аборта овец[6],
Распространены повсеместно, особенно в сельскохозяйственных областях, традиционно занимающихся скотоводством — Поволжье, Северном Кавказе.
Примечания
- LPSN: Genus Brucella
- Атлас по медицинской микробиологии, вирусологии и иммунологии / Под ред. А. А. Воробьева, А. С. Быкова. — М.: Медицинское информационное агентство, 2003. — С. 57. — ISBN 5-89481-136-8.
- Williamson, Blair. Victory in the Battle against Brucella: From bench to battlefield. Vital Record: News from Texas A&M HSC.
- GOLD Database. Дата обращения: 1 октября 2012.
- Brucella genomes in PATRIC. PATRIC. Дата обращения: 22 октября 2012. Архивировано 10 мая 2013 года.
- Литусов Н.В. ВОЗБУДИТЕЛИ БРУЦЕЛЛЕЗА:Иллюстрированное учебное пособие. — Екатеринбург: МИА, 2012. — С. 38.
Литература
- Поздеев, О. К. Медицинская микробиология. — М.: ГЭОТАР-МЕД, 2002. — 394—396 с. — С. 768. — ISBN 5-9231-0249-8.
- Саркисян Н.С., Куличенко А.Н., Ковалевич Н.И., Санникова И.В., Махиня О.В. Комплексная оценка цитокинового профиля, протеинограмм и белков острой фазы воспаления у пациентов с острым бруцеллезом. Иммунология. 2021; 42 (5): 511-517. DOI: https://doi.org/10.33029/0206-4952-2021-42-5-511-517